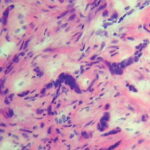

Morpheaform basal cell carcinoma =الكارسينوما قاعدية الخلايا الصلابية الشكل
|
Basal Cell Carcinoma Basal cell carcinoma (BCC) is a malignant neoplasm derived from nonkeratinizing cells that originate in the basal layer of the epidermis. If left untreated, BCC will continue to invade locally and may result in substantial tissue damage that compromises function and cosmesis. Metastasis is an extremely rare event. EPIDEMIOLOGY BCC is the most common cancer in humans. It is estimated that over 1 million new cases occur each year in the United States. BCC is more common in elderly individuals but is becoming increasingly frequent in people younger than 50 years of age. Christenson et al. noted a disproportionate increase in BCC in women under age 40. The malignancy accounts for approximately 75 percent of all non-melanoma skin cancers and almost 25 percent of all cancers diagnosed in the United States. The tumor characteristically develops on sun-exposed skin of lighter-skinned individuals, with 20 percent occurring on the nose. Men are affected slightly more often than are women. Levi et al. reported that the incidence of BCC rose steadily in the Swiss Canton of Vaud between 1976 and 1998 to levels of 75.1 in 100,000 in males and 66.1 in 100,000 in females.3,4 A study of non-melanoma skin cancers in Aruba supported these findings.5 In that study, BCC was the most common type of skin cancer diagnosed between 1980 and 1995. Tumors were more frequent in patients older than 60 years of age, and 57 percent were in men. The highest percentage of lesions occurred on the nose (20.9 percent), followed by other sites on the face (17.7 percent). Risk factors for BCC have been well characterized and include ultraviolet light (UVL) exposure, light hair and eye color, northern European ancestry, and inability to tan.1 Patients with BCC are at increased risk for melanoma but not for other internal malignancies. Bower et al. reported that individuals with BCC had a threefold increased risk for melanoma but no increased risk for any other type of cancer. ETIOLOGY AND PATHOGENESIS The pathogenesis of BCC involves exposure to UVL, particularly the ultraviolet B spectrum (290 to 320 nm) that induces mutations in tumor suppressor genes. Some studies indicate that intermittent brief holiday exposures may place patients at higher risk than occupational exposure. Ramani and Bennett reported a significantly higher incidence of BCCs in World War II servicemen stationed in the Pacific theater than in those stationed in Europe. This suggests that several months or years of intense exposure to UVL may have deleterious long-term effects. Other factors that appear to be involved in the pathogenesis include mutations in regulatory genes, exposure to
The propensity to develop multiple BCCs may be inherited. Included among heritable conditions predisposing to the development of this epithelial cancer are nevoid basal call carcinoma syndrome or basal cell nevus syndrome (BCNS), Bazex syndrome,15 and Rombo syndrome. Patients with BCNS may develop hundreds of BCCs and may exhibit a broad nasal root, borderline intelligence, jaw cysts, palmar pits, and multiple skeletal abnormalities. BCNS occurs due to mutations in the tumor suppressor PTCH gene Bazex syndrome is transmitted in an X-linked dominant fashion.15 Patients have multiple BCCs, follicular atrophoderma, dilated follicular ostia with icepick scars, hypotrichosis, and hypohidrosis. In contrast, Rombo syndrome is transmitted in an autosomal dominant fashion. Patients have vermiculate atrophoderma, milia, hypertrichosis, trichoepitheliomas, BCCs, and peripheral vasodilation. Hypohidrosis is not a feature of Rombo syndrome . The role of the immune system in the pathogenesis of skin cancer is not completely understood. Immunosuppressed patients with lymphoma or leukemia and patients who have received an organ transplant13 have a marked increase in the incidence of squamous cell carcinoma but only a slight increase in the incidence of BCC. Bastiaens et al. found that transplant recipients developed more BCCs on the trunk and arms than did nonimmunosuppressed patients.20 Patients with human immunodeficiency virus infection develop BCCs at the same rate as immunocompetent individuals, based on similar risk factors.21 Immunosuppressed long-term alcoholics tend to develop infiltrative BCCs with increased frequency. A potential link between UVL and decreased immunity has been suggested by Gutierrez-Steil et al., who demonstrated that UVL-induced BCCs express Fas ligand (CD95L).23 They further showed that these cells were associated with CD95-bearing T cells undergoing apoptosis. This represents a potential mechanism by which UVL might help tumor cells avoid being killed by cytotoxic T lymphocytes. ▪ CLINICAL MANIFESTATIONS Presentation The presence of any friable, non-healing lesion should raise the suspicion of skin cancer. Frequently, BCC is diagnosed in patients who state that the lesion bled briefly then healed completely, only to recur. BCC usually develops on sun-exposed areas of the head and neck but can occur anywhere on the body. Features include translucency, ulceration, telangiectasias, and the presence of a rolled border. Characteristics may vary for different clinical sub-types, which include nodular, superficial, morpheaform, and pigmented BCCs and fibroepithelioma of Pinkus (FEP). Basal Cell Carcinoma Sub-Types NODULAR BASAL CELL CARCINOMA Nodular BCC is the most common clinical sub-type of BCC It occurs most commonly on the sun-exposed areas of the head and neck and appears as a translucent papule or nodule depending on duration. There are usually telangiectasias and often a rolled border. Larger lesions with central necrosis are referred to by the historical term rodent ulcer (Fig. 115-2). The differential diagnosis of nodular BCC includes traumatized dermal nevus and amelanotic melanoma. PIGMENTED BASAL CELL CARCINOMA Pigmented BCC is a sub-type of nodular BCC that exhibits increased melanization. Pigmented BCC appears as a hyperpigmented, translucent papule, which may also be eroded (Fig. 115-3). The differential diagnosis includes nodular melanoma. SUPERFICIAL BASAL CELL CARCINOMA Superficial BCC occurs most commonly on the trunk and appears as an erythematous patch (often well demarcated) that resembles eczema An isolated patch of “eczema” that does not respond to treatment should raise suspicion for superficial BCC. MORPHEAFORM (SCLEROSING) BASAL CELL CARCINOMA Morpheaform BCC is an aggressive growth variant of BCC with a distinct clinical and histologic appearance. Lesions of morpheaform BCC may have an ivory-white appearance and may resemble a scar or a small lesion
FIBROEPITHELIOMA OF PINKUS FEP classically presents as a pink papule, usually on the lower back. It may be difficult to distinguish from an acrochordon or skin tag. ▪ BIOLOGIC BEHAVIOR Local Invasion The greatest danger of BCC results from local invasion . In general, BCC is a slow-growing tumor that invades locally rather than metastasizes. The doubling time is estimated to be between 6 months and 1 year. If left untreated, the tumor will progress to invade subcutaneous tissue, muscle, and even bone. Anatomic fusion planes appear to provide a lowresistance path for tumor progression. Tumors along the nasofacial or retroauricular sulcus may be extensive. In one informative case, a patient documented the progression of his own tumor with photographs over a 27-year period. The lesion, which encompassed an entire side of the face, including the maxillary sinus, apparently doubled over a 10-year period and grew rapidly in the 2 years before hospital admission. This scenario occurs in the context of physical or psychiatric disability that interferes with judgment or access to health care. In another case, a 35-cm BCC on the back of a 65-year-old man recurred after wide local excision and x-ray therapy (XRT), resulting in spinal cord compression. Lethal extension to the central nervous system from aggressive scalp BCC has been reported. Perineural Invasion Perineural invasion is uncommon in BCC and occurs most often in histologically aggressive or recurrent lesions. In one series, Niazi and Lamberty identified perineural invasion in fewer than 0.2 percent of cases.31 In that series, perineural BCC was seen most often with recurrent tumors located in the preauricular and malar areas. Ratner et al. found a higher incidence in their study (3.8 percent). Leibovitch et al. reported perineural spread in more than 50 percent of periocular BCCs eventuating in orbital invasion. These tumors required extensive surgery and in some cases exenteration Perineural spread may manifest as pain, paresthesias, weakness, or paralysis. The presence of focal neurologic symptoms at the site of a previously treated skin cancer should raise concern about nerve involvement. Metastasis Metastasis of BCC occurs only rarely, with rates varying from 0.0028 percent to 0.55 percent.34-36 Involvement of lymph nodes and lungs is most common. Von Domarus et al. reported five cases of metastatic BCC in which perineural or intravascular invasion had been noted in three.37 Squamous differentiation was not observed in the primary tumors in the cases they presented but was noted in two of five cases of metastatic cancer. Overall, squamous differentiation was present in 15 percent of the primary or metastatic tumors from the 170 cases reviewed. Aggressive histologic characteristics, including morpheaform features, squamous metaplasia, and perineural invasion, have been identified as risk factors for metastasis.36 DIAGNOSIS Diagnosis of BCC is accomplished by accurate interpretation of the skin biopsy results. The preferred biopsy methods are shave biopsy, which is often sufficient, and punch biopsy. A sterilized razor blade, which can be precisely manipulated by the operator to adjust the depth of the biopsy specimen, is often superior to a No. 15 scalpel for shave biopsies. A punch biopsy may be useful for flat lesions of morpheaform BCC or for recurrent BCC occurring in a scar.
HISTOPATHOLOGY Histopathologic features vary somewhat with sub-type, but most BCCs share some common histologic characteristics. The malignant basal cells have large nuclei and relatively little cytoplasm. Although the nuclei are large, they may not appear atypical. Usually, mitotic figures are absent. Frequently, retraction of stroma from tumor islands is present, creating peritumoral lacunae that are helpful in histopathologic diagnosis. Nodular Basal Cell Carcinoma Nodular BCCs account for half of all BCCs and are characterized by nodules of large basophilic cells and stromal retraction . The term micronodular BCC is used to describe tumors with multiple microscopic nodules smaller than 15µm . Pigmented Basal Cell Carcinoma Pigmented BCC shows histologic features similar to those of nodular BCC but with the addition of melanin.38 Approximately 75 percent of BCCs contain melanocytes, but only 25 percent contain large amounts of melanin. The melanocytes are interspersed between tumor cells and contain numerous melanin granules in their cytoplasm and dendrites. Although the tumor cells contain little melanin, numerous melanophages populate the stroma surrounding the tumor. Superficial Basal Cell Carcinoma Superficial BCC is characterized microscopically by buds of malignant cells extending into the dermis from the basal layer of the epidermis. The peripheral cell layer shows palisading. There may be epidermal atrophy, and dermal invasion is usually minimal. This histologic sub-type is encountered most often on the trunk and extremities but may also appear on the head and neck. There may be a chronic inflammatory infiltrate in the upper dermis. Morpheaform Basal Cell Carcinoma Morpheaform or infiltrative BCC consists of strands of tumor cells embedded within a dense fibrous stroma . Tumor cells are closely packed and, in some cases, only one cell thick. Strands of tumor extend deeply into the dermis. The cancer is often larger than the clinical appearance indicates. Recurrent BCC may also demonstrate infiltrating bands and nests of cancer cells embedded within the fibrous stroma of scar.
Fibroepithelioma of Pinkus In FEP, long strands of interwoven basiloma cells are embedded in fibrous stroma. Histologically, FEP shows features of reticulated seborrheic keratoses and superficial BCC. |